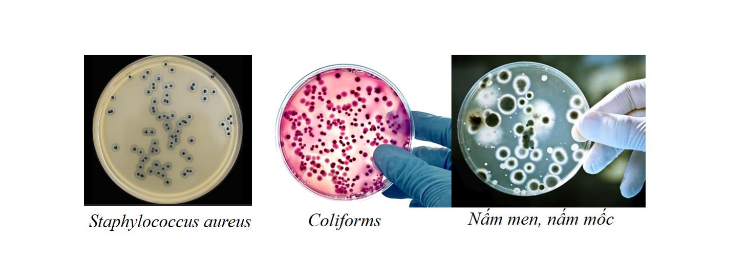

Công ty cổ phần QUANALAB – một trong những đơn vị hàng đầu ứng dụng công nghệ cao trong lĩnh vực kiểm nghiệm, khảo nghiệm, thử nghiệm và xét nghiệm thực phẩm và các sản phẩm tiêu dùng. Được thành lập với mong muốn sẽ là đối tác đáng tin cậy của các tổ chức, doanh nghiệp và cá nhân, công ty cổ phần QUANALAB luôn đặt chất lượng lên hàng đầu, cam kết mang đến những dịch vụ chuyên nghiệp; đảm bảo tính chính xác, khách quan và trung thực
Vệ sinh an toàn thực phẩm là chìa khóa vàng cho sức khỏe của mỗi người dân và cộng đồng. Sử dụng thực phẩm không đảm bảo vệ sinh an toàn thực phẩm có thể gây ngộ độc cấp tính dẫn đến tử vong hay gây ra nhiều căn bệnh mãn tính ảnh hưởng đến sức khỏe và tính mạng của người sử dụng.

Hình 1: Một số vi sinh vật gây ngộ độc nghiêm trọng có trong thực phẩm
Theo thống kê của Bộ Y tế, tính đến ngày 30/11/2024 trong phạm vi quản lý của bộ đã phát hiện 22.073 cơ sở sản xuất, kinh doanh thực phẩm vi phạm về các quy định về an toàn thực phẩm và ghi nhận 131 vụ ngộ độc thực phẩm. Nguyên nhân chính dẫn tới nhiều vụ ngộ cấp tính trong thời gian gần đây là do các vi sinh vật gây bệnh có mặt trong thực phầm như Salmonella, E.coli, C.botulinum, S. aureus, L.monocytogenes… Bên cạnh đó, hóa chất cũng là nguyên nhân chính gây ô nhiễm thực phẩm. Hóa chất được sử dụng rất thường xuyên trong ngành công nghiệp thực phẩm từ khâu nuôi trồng nguyên liệu thực phẩm như thuốc kháng sinh, chất phòng trừ sâu bệnh, thuốc
Hình 1: Một số vi sinh vật gây ngộ độc nghiêm trọng có trong thực phẩm bảo vệ thực vật đến khâu sản xuất chế biến như chất bảo quản, chất tẩy rửa, chất khử trùng, phụ gia thực phẩm,…Việc sử dụng hóa chất sai quy cách, liều lượng, sai mục đích sẽ dẫn tới tồn dư các loại chất độc hại trong thực phẩm. Đây là loại ô nhiễm khó kiểm soát, có thể gây ngộ độc cấp tính và các bệnh mãn tính ở người.

Hình 2: Một số hóa chất tồn dư trong thực phẩm gây ảnh hưởng tới sức khỏe con người
Việc không đảm bảo vệ sinh an toàn thực phẩm không chỉ tác động tiêu cực đến sức khỏe người tiêu dùng, mà còn gây tổn hại nghiêm trọng đến uy tín của các doanh nghiệp và nền kinh tế quốc gia. Do vậy, đảm bảo an toàn thực phẩm là trách nhiệm của cả cộng đồng, từ các cấp ban ngành của cơ quan quản lý đến người sản xuất, kinh doanh và người tiêu dùng. Hiện nay, mỗi quốc gia đều có những quy định chặt chẽ về vệ sinh an toàn thực phẩm để bảo vệ sức khỏe người dân và duy trì sự ổn định của xác hội như luật an toàn thực phẩm và các tiêu chuẩn, quy chuẩn quốc gia quy định về thông số kỹ thuật, giới hạn an toàn cho phép có trong thực phẩm.
Kiểm nghiệm, thử nghiệm, khảo nghiệm và xét nghiệm là một khâu không thể thiếu trong chuỗi cung ứng thực phẩm và các sản phẩm tiêu dùng; và là công cụ hữu hiệu để xác định một sản phẩm thực phẩm có an toàn và đạt chuẩn yêu cầu theo các tiêu chuẩn quốc gia, tiêu chuẩn quốc tế quy định hay không. Ngành kiểm nghiệm đang đóng vai trò hỗ trợ quan trọng trong việc bảo vệ sức khỏe cộng đồng, ngăn chặn các vụ ngộ độc thực phẩm, và đảm bảo sự cạnh tranh công bằng trên thị trường. Bên cạnh đó, nó còn giúp các doanh nghiệp nâng cao chất lượng sản phẩm, duy trì uy tín của thương hiệu và đáp ứng các yêu cầu ngày càng khắt khe của người tiêu dùng và các quy định của pháp luật
Tại QUANALAB, tất cả các quy trình phân tích dùng để kiểm nghiệm đều được tham chiếu theo phương pháp tiêu chuẩn, quy chuẩn của Việt Nam cũng như trên thế giới như TCVN, QCVN, ISO, AOAC, … và toàn bộ các quy trình này đều được thẩm định và thực hiện theo quy định của ISO/IEC 17025. Các phương pháp đều được kiểm tra đánh giá tay nghề nhân viên, tham gia so sánh liên phòng và thực hiện chương trình thử nghiệm thành thạo nhằm mục đích đảm bảo tính chính xác của kết quả kiểm nghiệm mang lại giá trị tốt đẹp nhất cho khách hàng.

Hình 3: Các thiết bị sử dụng trong kiểm nghiệm thực phẩm tại công ty cổ phần QUANALAB
QUANALAB cung cấp các dịch vụ kiểm nghiệm các chỉ tiêu vi sinh và các chỉ tiêu hóa lý trên đa dạng các nền mẫu như nước, thực phẩm, nông sản, mỹ phẩm, thủy hải sản, thức ăn chăn nuôi và các sản phẩm tiêu dùng khác. Nhóm các chỉ tiêu vi sinh bao gồm: Tổng số vi sinh vật hiếu khí, tổng số nấm men – nấm mốc, coliforms, Enterobacteria, Shigella, Salmonella, V. cholera, S. aureus, V. parahaemolyticus, B. cereus, L. monocytogenes …
Hình 4: Các đĩa nuôi cấy phát hiện vi sinh vật trong thực phẩm
Nhóm các chỉ tiêu hóa trong thực phẩm bao gồm: Các chỉ tiêu cảm quan (trạng thái, mùi vị, màu sắc); Các chỉ tiêu dinh dưỡng (protein, lipit, carbohydrate, DHA, Omega, acid amin …); Hàm lượng kim loại nặng (chì (Pb), cadimi (Cd), asen (As), thủy ngân (Hg) …); Dư lượng hormone tăng trưởng và thuốc thú y; Dư lượng thuốc bảo vệ thực vật (trifluralin, chlorpyrifos, fipronil, cypermethrin, dichlorvos ...); Phân tích kháng sinh nhóm (fluoroquinolone, nitrofuran và các chất chuyển hóa, amphenicol, tetracycline, ..); Các chất độc hại khác (histamin, ure, formaldehyde, …)

Hình 5: Các chỉ tiêu hóa học trong thực phẩm được phân tích
QUANALAB không chỉ cung cấp dịch vụ kiểm nghiệm, thử nghiệm, khảo nghiệm, xét nghiệm mà còn đồng hành cùng doanh nghiệp trong việc tư vấn cập nhật các quy định cơ chế theo pháp luật hiện hành để nâng cao chất lượng sản phẩm giúp doanh nghiệp đáp ứng các tiêu chuẩn pháp lý khắt khe và tạo dựng giá trị bền vững cho thương hiệu. Sự hài lòng của khách hàng là động lực để chúng tôi không ngừng phấn đấu. Chúng tôi cam kết:
Công ty cổ phần QUANALAB rất mong được hợp tác và trở thành đối tác tin cậy của khách hàng trên con đường nâng cao chất lượng sản phẩm và cuộc sống.
Công ty Cổ phần QUANALAB
Địa chỉ: số 16, ngõ 48 Chu Huy Mân, Phúc Đồng, Long Biên, Hà Nội.
Website: quanalab.vn
Hotline:
Email: kn.quanalab@gmail.com
Giao hàng trên toàn quốc
Thành tiền: